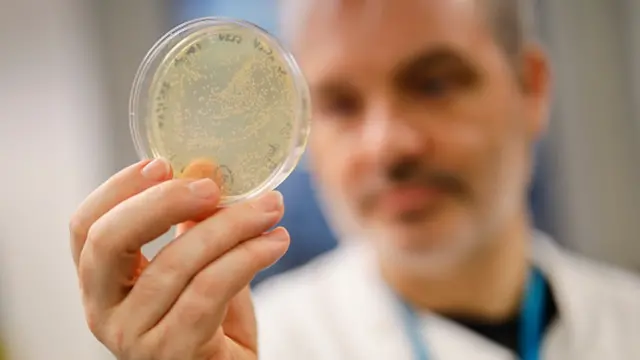
Virus

Azərbaycan: koronavirusun iqtisadiyyata təsiri ilə bağlı 1 milyard ayrılıb

Şəklin mənbəyi, Anadolu Agency/Getty Images
Koronavirus pandemiyasının Azərbaycan iqtisadiyyatına mənfi təsirinin azaldılması ilə bağlı tədbirlərin maliyyələşdirilməsi üçün 1 milyard manat ayrılıb.
Bu barədə Prezident İlham Əliyev cümə axşamı günü qərar verib.
Cənab Əliyev İqtisadiyyat, Maliyyə, Əmək və Əhalinin Sosial Müdafiə nazirləri və Mərkəzi Bank sədrinin rəhbərliyi ilə, müvafiq olaraq, dörd işçi qrup yaradılması barədə də sərəncam verib.
İşçi qrupların tərkibi barədə təklifləri müvafiq qurumlar tərəfindən bir gün müddətində Nazirlər Kabinetinə təqdim olunmalı, Nazirlər Kabineti isə 10 gün ərzində ayrılacaq vəsaitin mənbəyi barədə təkliflər verməlidir.
İqtisadiyyat nazirinin rəhbərliyi ilə İşçi Qrup 15 gün müddətində pandemiyanın yaxın və orta müddətlərdə ölkənin biznes mühitinə mənfi təsirini azaltmaq, habelə bu dövrdə ölkədə iqtisadi artımın davam etməsinə dəstək göstərmək məqsədilə müvafiq təkliflərini hazırlamalıdır.
Maliyyə nazirinin rəhbərliyi ilə İşçi Qrup 25 gün ərzində iqtisadi fəaliyyət sahələri və sahibkarlıq fəaliyyəti göstərən hüquqi və fiziki şəxslərə yardımla bağlı təkliflər verməlidir.
Əmək və Əhalinin Sosial Müdafiəsi nazirinin rəhbərliyi ilə İşçi Qrup bir ay müddətinə muzdlu işçilərin sosial müdafiəsi və onlara dövlət dəstəyinin göstərilməsi, ölkə əhalisinin aztəminatlı hissəsinin sosial müdafiəsinin gücləndirilməsi və digər məsələlərdə təkliflər təqdim etməlidir.
Mərkəzi Bankının sədrinin rəhbərliyi ilə İşçi Qrup iki ay müddətində manatının məzənnəsinin və istehlak qiymətlərinin sabitliyinin dəstəklənməsi, eləcə də makroiqtisadi sabitlik üçün lazım olan əlavə tədbirlər barədə məlumat verməlidir.


Prezident İlham Əliyev Cümə axşamı günü Azərbaycanda Koronavirusla Mübarizəyə Dəstək Fondu yaradılması barədə sərəncam verib.
Sərəncamda deyilir ki, fondun məqsədi "Azərbaycanda koronavirus infeksiyasının yayılmasının qarşısını almaq və onunla mübarizə istiqamətində həyata keçirilən tədbirlərə maliyyə dəstəyini təmin etmək" olacaq.
Qərarda fondun dekabrın 31-dək fəaliyyət göstərəcəyi, bu müddətin Prezident tərəfindən uzadıla biləcəyi qeyd olunub.
Şəklin mənbəyi, AFP/Getty Images
İlham Əliyev digər bir sərəncamla Fonda Prezidentinin ehtiyat fondundan ilkin olaraq 20 milyon manat ayırıb.
Bu vəsaitdən tibb işçilərinin mükafatlandırılması və onlara maddi yardım göstərilməsi, tibbi müəssisələrin təkmilləşdirilməsi, xüsusi rejimli tibb müəssisələrinin formalaşdırılması, tibb sahəsində mütəxəssislərin hazırlanması və digər məqsədlər üçün istifadə olunacağı bildirilib.
Martın 19-da Azərbaycanda 10 yeni koronavirus infeksiyasına yoluxma halı qeydə alınıb, Nazirlər Kabineti yanında operativ qərargah bildirib.
Qərargahın cümə axşamı günü verdiyi məlumatda deyilir ki, infeksiyaya yoluxmuş həmin şəxslər müxtəlif vaxtlarda Almaniya, Fransa, Türkiyə və İrandan Azərbaycana qayıdıblar.
"Xüsusi rejimli xəstəxanalara yerləşdirilən və müşahidə altında olan pasiyentlər özlərini normal hiss edirlər, səhhətləri stabil qiymətləndirilir", - qərargahın məlumatında deyilir.
Nazirlər Kabineti hazırda Azərbaycanda 33 nəfər aktiv koronavirus xəstəsinin xüsusi rejimli müəssisələrdə həkim nəzarəti altında saxlanıldığını, onların müalicəsi ilə bağlı müvafiq tədbirlərin davam etdirildiyini qeyd edib.
Rəsmi qurumlara əsasən, indiyədək Azərbaycanda koronavirusdan 11 nəfər sağalıb, bir nəfər ölüb.










